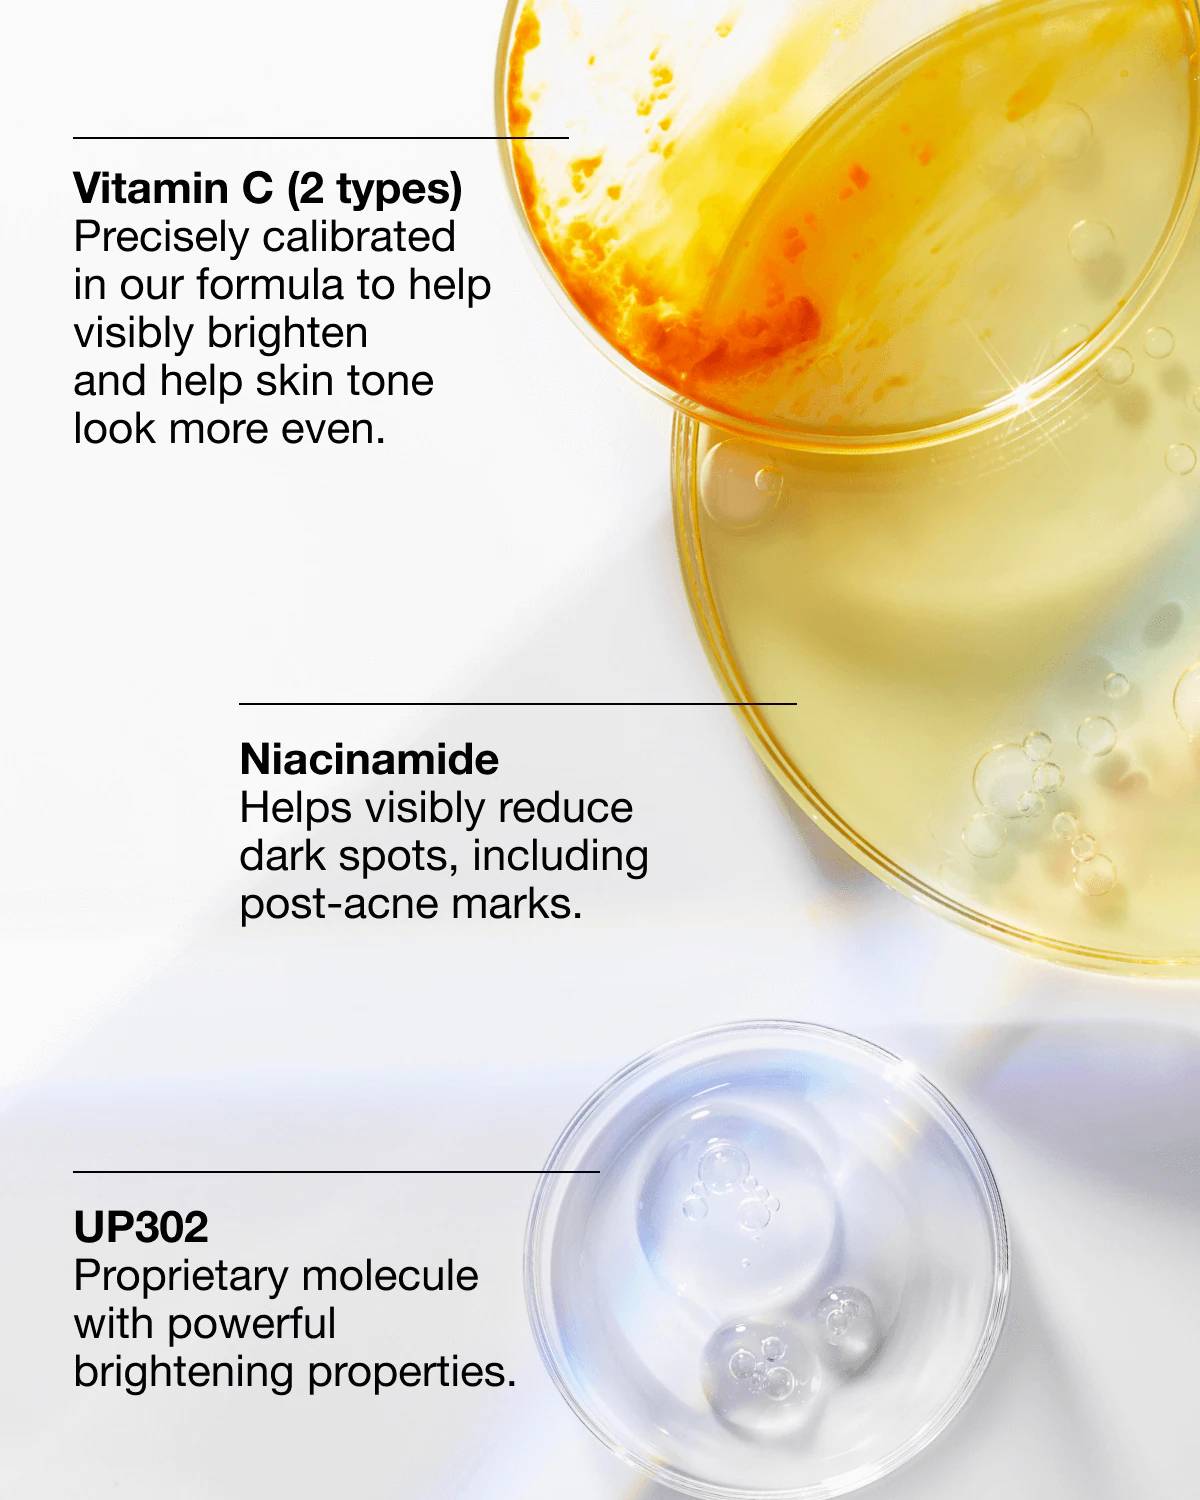

دستهبندی: مراقبت پوست






سرم ضد لک و درخشانکننده کلینیک
برند: کلینیک
امکان قسطبندی برحسب اعتبار تربپی
۴ قسط ماهانه. بدون سود، چک و ضامن.
سرم ضد لک و روشنکننده کلینیک (Clinique Even Better Clinical Dark Spot Corrector) است که یکی از قویترین و معروفترین محصولات درمانی این برند محسوب میشود.
این یک سرم تخصصی برای درمان لکهای پوستی است. فرمولاسیون آن به گونهای طراحی شده که:
رفع لک: لکهای ناشی از آفتاب، جای جوش و افزایش سن را کمرنگ میکند.
ترکیبات قوی: حاوی ویتامین C و نیاسینامید است که به شفافیت و یکدستی رنگ پوست کمک میکنند.
* پیشگیری: از ایجاد لکهای جدید جلوگیری میکند.
حجم: ۳۰میل
دستهبندی: مراقبت پوست